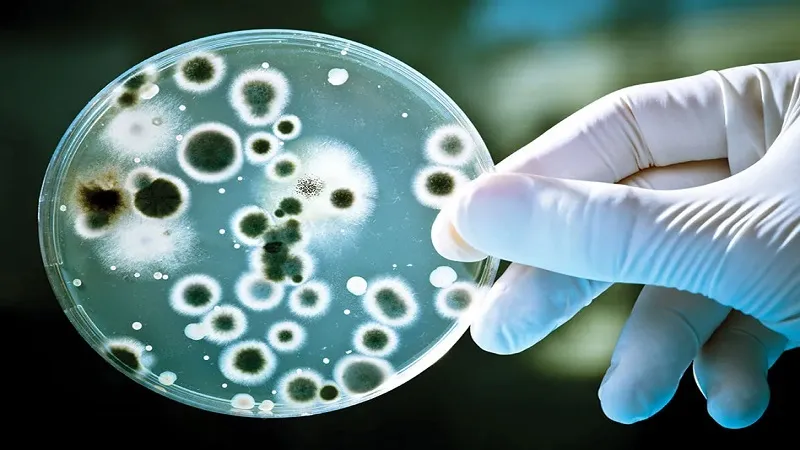
इंडोनेशिया ने रोगाणुरोधी प्रतिरोध की निगरानी के किफायती तरीके का किया परीक्षण, संयुक्त राष्ट्र ने दी चेतावनी

इंडोनेशिया ने रोगाणुरोधी प्रतिरोध की निगरानी के किफायती तरीके का किया परीक्षण, संयुक्त राष्ट्र ने दी चेतावनी
‘सुपरबग’ के बढ़ने से 2050 तक वैश्विक स्तर पर प्रति वर्ष हो सकती है एक करोड़ लोगों की मौत
बांडुंग। इंडोनेशिया के शोधकर्ताओं ने रोगाणुरोधी प्रतिरोध की निगरानी के एक किफायती तरीके का परीक्षण किया है जो विकासशील देशों के लिए एक महत्वपूर्ण उपकरण हो सकता है। इंडोनेशिया के शोधकर्ताओं ने रोगाणुरोधी प्रतिरोध में परिवर्तन को मापने के लिए एक किफायती, प्रभावी, अपेक्षाकृत त्वरित विधि प्रणाली का परीक्षण किया है जो विकासशील देशों को वैश्विक खतरे के रूप में देखी जाने वाली समस्या से लड़ने में मदद कर सकता है।
गहन प्रयोगशाला परीक्षण की आवश्यकता पर जोर देना कई देशों के लिए व्यावहारिक नहीं हो सकता है, ऐसे में इस तरह के दृष्टिकोण पर टिके रहने के बजाय उन्होंने गुणवत्ता नियंत्रण की विधि के रूप में विकसित ‘‘लॉट क्वालिटी एश्योरेंस सैंपलिंग’’ का आकलन किया। इस प्रणाली में छोटे नमूना आकारों का उपयोग करके जनसंख्या के रोगाणुरोधी प्रतिरोध का आकलन किया जा सकता है। पिछले महीने स्वास्थ्य मंत्रियों की बैठक में इस खतरे से व्यापक रूप से निपटने की प्रतिबद्धता के बाद जी20 के लिए यह अच्छी खबर है।
रोगाणुरोधी प्रतिरोध रोगाणुओं में उन दवाओं के प्रभाव को रोकने की क्षमता है जो उन्हें मारने के लिए होती हैं। इससे संक्रमण का इलाज करना कठिन हो जाता है और लंबे समय तक अस्पताल में रहना, अधिक महंगी देखभाल और मृत्यु का खतरा बढ़ सकता है। इंडोनेशिया में रोगाणुरोधी प्रतिरोध का उच्च स्तर अब एक ‘मूक महामारी’ बनता जा रहा है।
संयुक्त राष्ट्र ने चेतावनी दी है कि ‘सुपरबग’ के बढ़ने से 2050 तक वैश्विक स्तर पर प्रति वर्ष एक करोड़ लोगों की मौत हो सकती है और विश्व अर्थव्यवस्था पर इसका बुरा असर पड़ सकता है। कई अन्य देशों की तरह, रोगाणुरोधी दवाओं का अनुचित उपयोग और प्रतिरोध को उत्प्रेरित करने वाले खराब स्वच्छता और वायु प्रदूषण जैसे अन्य कारक इंडोनेशिया में प्रचलित हैं। 2015 में 68वीं विश्व स्वास्थ्य सभा ने रोगाणुरोधी प्रतिरोध पर वैश्विक कार्य योजना को अपनाया। यह बढ़ी हुई वैश्विक निगरानी के महत्व पर जोर देता है, खासकर निम्न और मध्यम आय वाले देशों में, जहां यह एक प्रमुख चिंता का विषय है।
वैश्विक कार्य योजना के प्रमुख स्तंभों में से एक बेहतर वैश्विक निगरानी के माध्यम से यह राष्ट्रीय रणनीतियों के लिए समर्थन है। प्रस्तावित वैश्विक निगरानी प्रणाली का लक्ष्य नैदानिक नमूनों के प्रयोगशाला परीक्षण का उपयोग करके प्रतिरोध की व्यापकता का अनुमान लगाना है। हालांकि, यह दृष्टिकोण विकासशील देशों में हमेशा व्यावहारिक नहीं होता है क्योंकि गुणवत्तापूर्ण सूक्ष्म जीव विज्ञान निदान तक उनकी सीमित पहुंच होती है। जनसंख्या-आधारित निगरानी एक पसंदीदा रणनीति है, लेकिन यह समय लेने वाली, श्रम-गहन और महंगी भी है। इसका मतलब है कि कई क्षेत्रों को तीव्र, व्यवहार्य और किफायती निगरानी रणनीति की आवश्यकता है।
ये भी पढ़ें:- G20 सम्मेलन में हिस्सा नहीं लेंगे चीनी राष्ट्रपति शी जिनपिंग, प्रतिनिधिमंडल का नेतृत्व करेंगे प्रधानमंत्री ली कियांग

11.png)
9.png)
6.png)

10.png)
5.png)
2.png)
7.png)
2.jpg)




